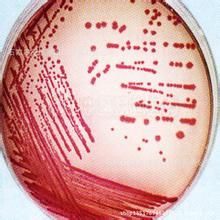
麥康凱瓊脂平板

產品標準:YZB/豫0006-2006,產品性能結構及組成:,麥康凱瓊脂平板生產廠家地址
生產場所
變更日期
備註
註冊號 豫食藥監械(準)字2010第2400069號
生產單位 鄭州安圖綠科生物工程有限公司
地址
郵編
產品名稱 麥康凱瓊脂平板
產品標準 YZB/豫0006-2006
產品性能結構及組成
有效期 2014.03.16
批准日期 2010.03.17
產品適用範圍
規格型號
附屬檔案
相關詞條
-
麥康凱瓊脂
麥康凱瓊脂成分有蛋白腖,脙腖。臨用時加熱溶化瓊脂,趁熱加入乳糖,冷至50~55℃時。
概要 成分 製法 -
麥康凱
麥康凱瓊脂培養基或是麥康凱培養基,具有中等強度選擇性,抑菌能力略強,主要抑制革蘭陽性菌,但有少數革蘭陰性菌也不生長,用於分離鑑定細菌的培養基。
名稱 用途 成分 製法 -
中國藥典微生物限度檢查法
稀釋級的供試液2ml,每1ml供試液可等量分注多個平皿,傾注瓊脂培養基...草芽抱桿菌的新鮮培養物至營養肉湯培養基中或營養瓊脂培養基上,培養18~24小時;接種白色念珠菌的新鮮培養物至改良馬丁培養基中或改良馬丁瓊脂培養基上...
基本介紹 相關介紹 檢驗量 計數 供試品檢查 -
實用醫學檢驗學
染色法姬姆薩染色法李什曼染色法麥格林瓦德染色法ICSH...
內容介紹 作品目錄 -
養禽場禽病檢驗手冊
培養基10.麥康凱瓊脂 11.沙門氏菌志賀氏菌瓊脂(簡稱SS瓊脂) 12....、平板挖洞法四、平板挖溝法五、瓊脂稀釋法六、泡沫塑膠片(或海棉)法第二節...乳糖膽鹽發酵管 12.乳糖發酵管 13.血清肉湯二、固體培養基1.營養瓊脂...
作品目錄 -
大腸埃希桿菌性胃腸炎
疾病名稱:大腸埃希桿菌性胃腸炎 大腸埃希桿菌性胃腸炎疾病分類:消化內科 疾病概述大腸埃希桿菌(Escherichia coli...
疾病概述 疾病描述 症狀體徵 疾病病因 病理生理 -
小腸結腸炎耶爾森氏菌
世代時間長,最短亦需40分鐘左右。在SS或麥康凱瓊脂上於25℃經24小時...、濕潤、扁平或稍隆起,透明或半透明;在麥康凱瓊脂上菌落淡黃色,如若微帶...鹼處理的其他食品增菌液分別接種於CIN-1瓊脂平板和改良Y 瓊脂平板...
基本信息 生物學特性 檢測方法 流行病學特點 -
遲鈍愛德華菌
的β型溶血環,在麥康凱瓊脂、膽鹽硫化氫乳糖瓊脂(DHL)、SS瓊脂等腸道菌...瓊脂、血瓊脂及某種腸道菌選擇性培養基(如SS瓊脂、DHL瓊脂、麥康凱瓊脂...愛德華菌。 檢驗程式 在麥康凱培養基上37℃培養24h,形成無色、圓形...
特性 危害 致病性 檢驗方法 血清學分型